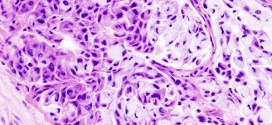

Los tumores hiliares. Es una enfermedad por la cual se forman células malignas cancerosas en los tejidos de la vesícula biliar es una enfermedad poco frecuente por la que se encuentran células cancerosas en los tejidos de la vesícula biliar. La vesícula biliar es un órgano glándula en forma de pera alargada situado por debajo del hígado, en la parte …
Leer MásEnfermedades
TUMORES MUCÍNOSOS DEL OVARIO
Los tumores mucínosos del ovario. Recordemos que la Trofología avanzada (binipatia), tiene el extraordinario poder de eliminación de las células cancerígenas (tumores), al igual que su maravillosa estrategia para detener el cáncer, al provocar la muerte de las células del cáncer por hambre. Esta es la maravillosa estrategia de la Trofología avanzada, hacer morir de hambre al cáncer mientras alimenta …
Leer MásUROTELIOMA
El urotelioma. Tumor maligno en general y especialmente el formado por células epiteliales, se presenta en el parénquima del riñón, es la forma más usual de cáncer y se origina en la proliferación de células epiteliales de los túbulos renales. Es más común en hombres que en las mujeres y no es común que afecte a menores de 35 años. …
Leer MásCARCINOMA BRONCOGÉNICO
El carcinoma broncogénico. Durante los primeros años de vida de una persona, las células normales se dividen más rápidamente para permitir el crecimiento. El cuerpo está compuesto por billones de células vivas. Las células normales del cuerpo crecen, se dividen formando nuevas células y mueren de manera ordenada. Una vez que se llega a la edad adulta, la mayoría de …
Leer MásCANCER METASTASICO DE PULMON
El cáncer metastásico de pulmón. Durante los primeros años de vida de una persona, las células normales se dividen más rápidamente para permitir el crecimiento. El cuerpo está compuesto por billones de células vivas. Las células normales del cuerpo crecen, se dividen formando nuevas células y mueren de manera ordenada. Una vez que se llega a la edad adulta, la …
Leer MásCÁNCER DE VULVA
El cáncer de vulva. Los virus del papiloma humano (VPH) de los tipos 16 y 18 son los principales tipos que se asocian al cáncer ginecológico y genital. A saber, sin olvidar a los demás. El cáncer de vulva es una enfermedad por la que se forman células malignas (cancerosas) en los tejidos de la vulva. El cáncer de vulva …
Leer MásHEPATITIS D
La hepatitis D (VHD, AGENTE DELTA), es la inflamación del hígado. Actualmente el virus infecta a 15 millones de personas en todo el mundo, casi todos adultos, y es muy común entre grupos de usuarios de drogas inyectadas y en los países que bordean el Mediterráneo. La mayoría de los niños con infección por VHD habitan en Italia y Grecia, …
Leer MásERITEMA NUDOSO
El eritema nudoso. Formación de eritemas localizados con máxima frecuencia en la cara ante-lateral de los miembros inferiores (en los pies y las piernas) acompañados por alteraciones en el estado general del afectado. El eritema nudoso se considera actualmente como una reacción mediada por inmunocomplejos (a saber) que se originan ante muy distintos agentes etiológicos. La inmunidad celular parece encontrarse …
Leer MásDISPLASIA MALIGNA CERVICAL
La displasia maligna cervical. Los virus del papiloma humano (VPH) de los tipos 16 y 18 son los principales tipos que se asocian al cáncer ginecológico y genital. A saber, sin olvidar a los demás. Tumor maligno casi siempre y especialmente el formado por células epiteliales. Durante los primeros años de vida de una persona, las células normales se dividen …
Leer MásCÁNCER DE LA OROFARINGE
Cáncer de la orofaringe. La orofaringe es la parte media de la faringe (garganta) detrás de la boca e incluye el tercio trasero de la lengua, el paladar blando, las partes laterales y posteriores de la garganta y las amígdalas. La faringe es un tubo hueco de alrededor de cinco pulgadas de largo que comienza detrás de la nariz y …
Leer MásCÁNCER DE ÍLEON
El cáncer de íleon. Tumor maligno en general y especialmente el formado por células epiteliales. El intestino delgado es una parte muy importante de nuestro sistema digestivo. Es que parte del tracto digestivo que conecta el estómago hasta el intestino grueso. Consiste en el duodeno, el yeyuno y el íleon. Aunque se conoce como intestino delgado, que mide alrededor de …
Leer MásBRADIFRENIA
La bradifrenia. Lentitud anormal en las respuestas afectivas e intelectuales o de las funciones intelectoafectivas. La Trofología avanzada cuenta también con un sistema fabuloso de restauración y regeneración Neurológica como lo es: TRNTA (Terapia de Restauración Neurológica Trofológica Avanzada): Es una estrategia terapéutica que combina métodos de la Trofología avanzada que basándose en las propiedades de recuperación del Sistema …
Leer MásATEROMATOSIS
La ateromatosis. Enfermedad ateromatosa (afecto de ateroma (depósito de lípidos en la pared arterial con producción de masas amarillentas de induración y reblandecimiento, que se observa en la aterosclerosis) o de su naturaleza) difusa de las arterias. Por: Salvador Gregori, binipatia.com Resumiendo: La ateromatosis se caracteriza por el desarrollo de una serie de lesiones en la pared arterial que van …
Leer MásCARCINOMA DE TRÁQUEA
El carcinoma de tráquea. La tráquea, es un tubo que conecta la faringe o la laringe a los pulmones, lo que permite el paso del aire. Se alinea con pseudoestratificado células ciliadas del epitelio columnar con células caliciformes que producen moco. Estas líneas de moco de las células de la tráquea para atrapar las partículas extrañas inhaladas que los cilios …
Leer MásCARCINOMA DE PAGET
El carcinoma de paget. Las glándulas mamarias están presentes en ambos sexos. En el hombre se mantienen rudimentarias toda la vida, en cambio en la mujer están poco desarrolladas hasta antes de la pubertad, cuando empieza el proceso de maduración. El máximo desarrollo de estas glándulas se produce durante el embarazo y especialmente en el período posterior al parto, durante …
Leer MásCARCINOMA DE LA CUERDA VOCAL IZQUIERDA
El carcinoma de la cuerda vocal izquierda. Las Cuerdas vocales son la parte del aparato fonador directamente responsable de la producción de la voz. No tienen forma de cuerda, sino que se trata de una serie de repliegues o labios membranosos. De hecho, su denominación correcta dejó de ser cuerdas vocales, ya que no son cuerdas, y pasó a ser …
Leer MásCARCINOMA DE CÉLULAS RENALES
El carcinoma de células renales. El cuerpo humano tiene dos riñones situados en la parte trasera del cuerpo, a cada lado de la columna vertebral, en la zona más baja de la caja torácica. Tienen la forma de dos alubias y más o menos el tamaño del puño: 12 cm de largo, y un peso de 150 gramos cada uno. Forman …
Leer MásCÁNCER DEL GLUTIS
El cáncer del glutis. Tumor, linfomas, neoplasia-s o muy similar pueden ser atrófico (el escirroso rodeado de tejido escleroso y atrófico), dermoide (el que contiene tapones de epitelio con masas coloideas), escirroso (el duro, fibroide y muy maligno, a saber), etc. El cáncer del glutis puede manifestarse a través de distintas marcas en la piel como manchas, protuberancias que aumentan …
Leer MásCÁNCER GÁSTRICO DISTAL
El cáncer gástrico distal. Ver cáncer de estómago.
Leer MásCÁNCER MICROCÍTICO DE PULMÓN
Fecha de revisión 30/08/2023 Escrito por: Salvador Gregori Escrivá Revisado científicamente por: Salvador Gregori Escrivá. El cáncer de pulmón microcítico (CPM) es un tipo de cáncer de pulmón que se caracteriza por su agresividad y rápida propagación. Representa aproximadamente el 10-15% de todos los casos de cáncer de pulmón y está fuertemente asociado con el tabaquismo. Se divide en dos …
Leer Más Binipatia e higienismo Medicina natural alternativa, plantas medicinales y remedios caseros naturales
Binipatia e higienismo Medicina natural alternativa, plantas medicinales y remedios caseros naturales